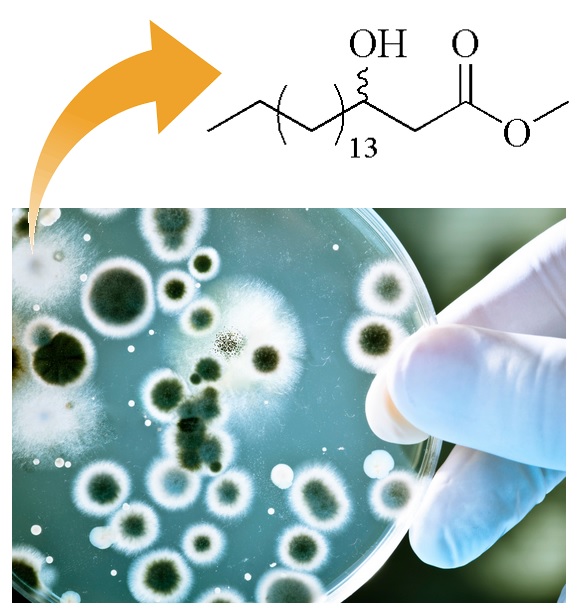

vol. 9, No. 3, 2017, p. 838-1392
Procedimentos de Submissão para Open Access
Os manuscritos submetidos na Revista Virtual de Química (RVq) adotam a implementação total do sistema open access, onde os autores contribuem com parte dos custos da Publicação de seus artigos. Ver mais...
É o Fim da Revisao por Pares?
Fernando de Carvalho da Silva
http://dx.doi.org/10.21577/1984-6835.20170052
3-Hidroxi-Octadecanoato de Metila, Biomarcador de Endotoxina: Uma Síntese Rápida
Ismael R. Amador, Jurandir P. Pinto, Fabio C. Sabino, Tiago O. Brito, Maria Cristina Solci
http://dx.doi.org/10.21577/1984-6835.20170053
Oxidaçao do Benzo(a)pireno em Matrizes Aquosas por Magnetita Dopada com Cobalto Combinada com Peróxido de Hidrogênio
Luciana B. Biazati, Thamyres F. M. Moreira, Renato Rodrigues Neto, Agostinho L. Teixeira, Marcos B. J. G. de Freitas, Maria de Fátima F. Lelis

http://dx.doi.org/10.21577/1984-6835.20170054
Leishmaniose: Aspectos Gerais Relacionados com a Doença, o Ciclo do Parasita, Fármacos Disponíveis, Novos Protótipos e Vacinas
Vinicius R. Blanco, Nailton M. Nascimento-Júnior

http://dx.doi.org/10.21577/1984-6835.20170055
Cálculo de Energia de Formaçao, Energia de Coesao e Estrutura de Bandas dos Filmes Finos Fe6Ar e Fe6Cl
Tatiéli P. Anibele, Antônio Vanderlei dos Santos

http://dx.doi.org/10.21577/1984-6835.20170056
Aspectos essenciais das Baterias Chumbo-Acido e Princípios Físico-Químicos e Termodinâmicos do seu Funcionamento
Rafael Luiz Carneiro; Joao Henrique A. Molina; Beatriz Antoniassi; Aroldo Geraldo Magdalena; Edilson M. Pinto

http://dx.doi.org/10.21577/1984-6835.20170057
Extraçao de Acido Cítrico do Limao e sua Utilizaçao para a Remoçao da Dureza da Agua: Um Método Alternativo para Aulas de Química
Eupídio Scopel, Patrick P. Conti, Cleocir José Dalmaschio, Vivian C. da Silveira

http://dx.doi.org/10.21577/1984-6835.20170058
Validaçao de Métodos por CG-EM para Análise de Carvacrol e trans-β-Cariofileno em Amostras Comerciais Contendo Oleos Essenciais
Francisco Carlos de Oliveira, André Luiz M. Camelo, Francisco Felipe M. da Silva, Francisco Thiago C. de Souza, Elisane Longhinotti, Francisco Geraldo Barbosa, Ronaldo F. Nascimento

http://dx.doi.org/10.21577/1984-6835.20170059
Screening Fitoquímico e Avaliaçao da Toxicidade de Croton heliotropiifolius Kunth (Euphorbiacea) frente à Artemia salina Leach
Jéssica A. G. Silva, Izabela R. Lima, Marllon Alex N. Santana, Tainá Maria S. da Silva, Maria Irene A. G. Silva, Sônia P. Leite

http://dx.doi.org/10.21577/1984-6835.20170060
Caracterizaçao Química e Energética de Epicarpo Residual do Pinhao Manso (Jatropha curcas L.) e Briquete Produzido
Joao Otávio P. Tomeleri, Larissa B. Valentim, Juliette P. da Silva, Franciane A. de Pádua, Fábio M. Yamaji

http://dx.doi.org/10.21577/1984-6835.20170061
Miniaturizaçao de uma Célula Eletroquímica em um Experimento Didático de Voltametria Cíclica: Economizando Reagentes e Minimizando a Geraçao de Resíduo
Isabela F. Paiola, Ana Carolina A. Faria, Diele A. G. Araújo, Regina M. Takeuchi, André L. Santos

http://dx.doi.org/10.21577/1984-6835.20170062
Um Compêndio de Inibidores de Tirosina Quinase: Fármacos Poderosos e Eficientes contra o Câncer
Dora Cristina S. Costa, Luana S. M. Forezi, Mariana Filomena C. Cardoso, Ruan Carlos B. Ribeiro, Angelo C. Pinto, Vitor F. Ferreira, Fernando de C. da Silva

http://dx.doi.org/10.21577/1984-6835.20170063
Influência de Diferentes Condiçoes de Armazenamento nas Propriedades Físico-Mecânicas de Briquetes
Paula Ayumi Konishi, Ana Larissa S. Hansted, Gabriela T. Nakashima, Elias Ricardo D. Padilla, Alessandra L. da Róz, Carlos R. Sette Júnior, Fábio M. Yamaji

http://dx.doi.org/10.21577/1984-6835.20170064
A Influência da Umidade em Propriedades Mecânicas de Briquetes Produzidos com Resíduos de Madeira (Eucalyptus sp. e Pinus sp.)
Diego A. da Silva, Alessandra L. da Róz, Ariane A. F. Pires, Alexandre M. de Carvalho, Gabriela T. Nakashima, Franciane A. de Pádua, Fabio M. Yamaji

http://dx.doi.org/10.21577/1984-6835.20170065
Caracterizaçao das Biomassas Casca de Pequi (Caryocar brasiliense Camb.) e Serragem de Madeira Teca (Tectona grandis) in natura e Modificadas com Acido Cítrico Segundo a Metodologia de Determinaçao de Grupos Básicos e Acidos de Boehm
Jéssica M. do Nascimento, Jorge D. de Oliveira

http://dx.doi.org/10.21577/1984-6835.20170066
Química de Produtos Naturais: Plantas que Testemunham Histórias
Márcia R. Almeida, Sabrina T. Martinez, Angelo C. Pinto

http://dx.doi.org/10.21577/1984-6835.20170068
As Isatinas do Professor Angelo
Sabrina T. Martinez, Vitor F. Ferreira

http://dx.doi.org/10.21577/1984-6835.20170069
Otimizaçao de Métodos Analíticos Usando Metodologia de Superfícies De Resposta - Parte I: Variáveis de Processo
Cleber G. Novaes, Regina T. Yamaki, Vanderlúcia F. de Paula, Baraquízio B. do Nascimento Júnior, Jeferson A. Barreto, Gisseli S. Valasques, Marcos A. Bezerra

http://dx.doi.org/10.21577/1984-6835.20170070
Otimizaçao da Síntese do Fluconazol: um Importante Fármaco Antifúngico da Classe dos Azóis
Cheyene A. C. Menozzi, Frederico S. Castelo-Branco, Rodolfo Rodrigo F. França, Jorge Luiz O. Domingos, Núbia Boechat

http://dx.doi.org/10.21577/1984-6835.20170071
Perfil Químico: Um Jogo para o Ensino da Tabela Periódica
Caroline G. Romano, Ana Letícia Carvalho, Isabella D. Mattano, Márcia R. M. Chaves, Beatriz Antoniassi

http://dx.doi.org/10.21577/1984-6835.20170072
Oleos Essenciais dos Frutos e Folhas de Kielmeyera coriacea: Atividade Antitumoral e Estudo Químico
Raiane S. Lemes, Géssica Carla S. Costa, Douglas Carlos S. Silva, Amanda B. Becceneri, Keylla U. Bicalho, Mayker Lazaro D. Miranda, Vania S. S. Diniz, Cristiane M. Cazal

http://dx.doi.org/10.21577/1984-6835.20170073
Métodos Sintéticos para a Preparaçao de Biarilas
Thais de B. da Silva, Fernando de C. da Silva, Vitor F. Ferreira

http://dx.doi.org/10.21577/1984-6835.20170074
Avaliaçao das Atividades Antiproliferativa e Antileishmania de 2-amino-5-aril-1,3,4-tiadiazóis Derivados do R-(+)-limoneno
Fábio Vandresen, Mariana R. Passos de Souza, Elizandra Britta, Expedito L. Silva, Joao E. de Carvalho, Ana Lúcia T. G. Ruiz, Celso V. Nakamura, Cleuza Conceiçao da Silva

http://dx.doi.org/10.21577/1984-6835.20170075
Flavonoides e Atividade Antioxidante das Folhas de Bauhinia longifolia (Bong.) Steud.
Alda Ernestina dos Santos, Cleber B. Barreto Junior, Ricardo M. Kuster

http://dx.doi.org/10.21577/1984-6835.20170076
Redes de Coordenaçao: Planejamento, Síntese, Topologia e Propriedades Fotofísicas
Vinícius Martins, Célia M. Ronconi

http://dx.doi.org/10.21577/1984-6835.20170077
Proteína Tirosina Fosfatase SHP-2 e sua Relaçao com o Câncer
Sheisi F. L. S. Rocha, Cristiane M. C. de Salles, Carlos Mauricio R. de Sant'Anna

http://dx.doi.org/10.21577/1984-6835.20170078
O Papel: Uma Breve Revisao Histórica, Descriçao da Tecnologia Industrial de Produçao e Experimentos para Obtençao de Folhas Artesanais
Maria Betânia d'Heni Teixeira, Robson Alves de Oliveira,Thérèse Hofmann Gatti, Paulo A. Z. Suarez

http://dx.doi.org/10.21577/1984-6835.20170079
Oleo Essencial das Flores de Eugenia klotzschiana (Myrtaceae): Composiçao Química e Atividades Tripanocida e Citotóxica In Vitro
Nárgella S. Carneiro, José Milton Alves, Cassia Cristina F. Alves, Viviane R. Esperandim, Mayker Lazaro D. Miranda

http://dx.doi.org/10.21577/1984-6835.20170080
Editoria da RVq - Editoria da RVq - PubliSBQ
Instituto de Química, Universidade Federal Fluminense,
Campus do Valonguinho, 24020-141, Centro, Niterói-RJ, Brasil
E-mail: rvq@sbq.org.br

